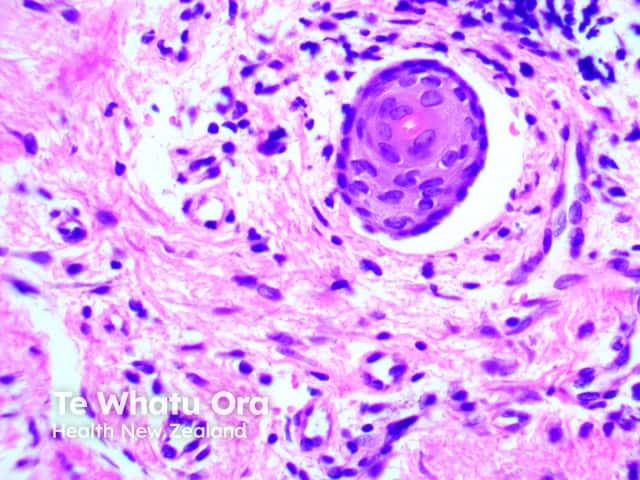
Figure 5

Main menu
Common skin conditions
NEWS
Join DermNet PRO
Read more
Quick links
Autoimmune/autoinflammatory Diagnosis and testing
Authors: Dr Achala Liyanage, Dermatology Fellow, Waikato Hospital, Hamilton, New Zealand; Assoc Prof Patrick Emanuel, Dermatopathologist, Auckland, New Zealand. January 2015.
Introduction Histology Special studies Differential diagnosis
Brunsting-Perry cicatricial pemphigoid is a rare form of localised cicatritial pemphigoid, commonly occurring on head and neck region. Interestingly, it usually does not involve the mucosal membranes as seen in typical cicatricial pemphigoid. Clinical differential is localised bullous pemphigoid, in which there is hardly any scarring in comparison to Brunsting Perry cicatritial pemphigoid.
Microscopy reveals subepidermal blistering with various admixture of inflammatory cell infiltrate. Early lesions may show small papillary microabscesses

Figure 1

Figure 2

Figure 3

Figure 4
Figure 5

Figure 6
Images provided by Dr Duncan Lamont, Waikato Hospital
Immunofluorescence shows basement membrane zone IgG and/or C3.
Electron microscopy reveals the split in the sublamina densa with preserved basal lamina and anchoring fibrils on the roof of the blister.
Localised bullous pemphigoid